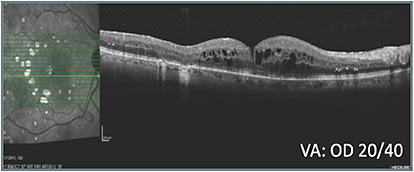
B: Status before treatment class switch OD
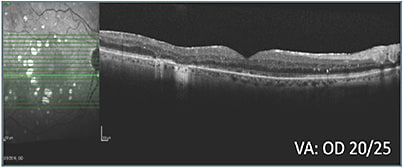
E: Status 28 weeks after treatment class switch OD
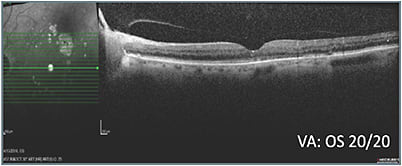
G: Status 12 weeks after treatment class switch OS

When this 69-year-old male with a history of PDR, DME, and multiple treatments, including laser, was referred from another practice, it was noted that he had poor response to prior treatment. The patient was pseudophakic and did not have glaucoma. His visual acuity was 20/50 OD and 20/30 OS. OCT indicated the need for treatment (A).

A series of treatments, during the course of which vision ranged from 20/50 to 20/25, failed to resolve the macular edema (B). With vision in the right eye consistently worse than in the left eye and worsening, and the patient experiencing hardship remaining away from home for treatment, an alternative class of therapy was initiated and led to improved retinal anatomy (C, D, & E). Intraocular pressure (IOP) increased to 25 mm Hg and was observed without treatment. When pressure increased to 28 mm Hg, the patient was started on a topical IOP-lowering drop, which lowered the pressure to 19 mm Hg. The right eye has remained fluid free on the alternative class of therapy and a single IOP-lowering agent.

The left eye also received the alternative class of therapy and, similarly to the right eye, achieved a positive response (G & H). This eye, too, has continued to do well on the alternative therapy and a single IOP-lowering agent that was added when the pressure increased to 26 mm Hg.